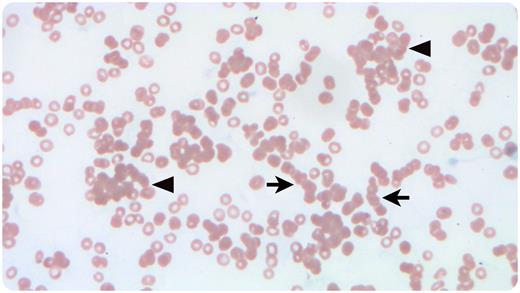
graphic

A 44-year-old woman, blood group A, with mycosis fungoides received a group O matched unrelated donor hematopoietic progenitor cell transplant followed by methotrexate and cyclosporine for graft-versus-host disease prophylaxis. Nine days posttransplant, the patient became febrile to 39.2°C. Physical examination results were benign. Complete blood count showed a precipitous hemoglobin decrease from the previous day’s level (to 4.9 from 9.6 g/dL, reference range 12-16 g/dL). Peripheral blood smear (Wright-Giemsa stain, 40× objective/total magnification ×400) showed marked anemia, rouleaux (arrows), and agglutinates (arrowheads). Schistocytes were absent. Further workup demonstrated elevated lactate dehydrogenase (697 U/L, reference range 60-100 U/L) and direct hyperbilirubinemia (total 3.0 mg/dL, reference range 0.3-1.2 mg/dL; direct 1.5 mg/dL, reference range 0-0.3 mg/dL). Direct Coombs test was positive for immunoglobulin-G and complement. An eluate prepared from the patient’s erythrocytes was nonreactive with group O erythrocytes but reactive with group A1 and A2 erythrocytes. Veno-occlusive disease and microangiopathic hemolytic anemia were ruled out. Methotrexate-induced, immune-mediated hemolytic anemia was deemed unlikely in light of eluate reactivity in the absence of methotrexate.
The findings suggest profound agglutination and hemolysis of recipient erythrocytes by donor-derived anti-A or A,B isohemagglutinins, a well-described risk 7 to 12 days after minor ABO-mismatch hematopoietic transplantation. After supportive care, including transfusion, hemoglobin increased to 7.9 g/dL, and rouleaux and agglutinates disappeared from peripheral smear.
Author notes
For additional images, visit the ASH Image Bank, a reference and teaching tool that is continually updated with new atlas and case study images. For more information, visit http://imagebank.hematology.org.

This feature is available to Subscribers Only
Sign In or Create an Account Close Modal